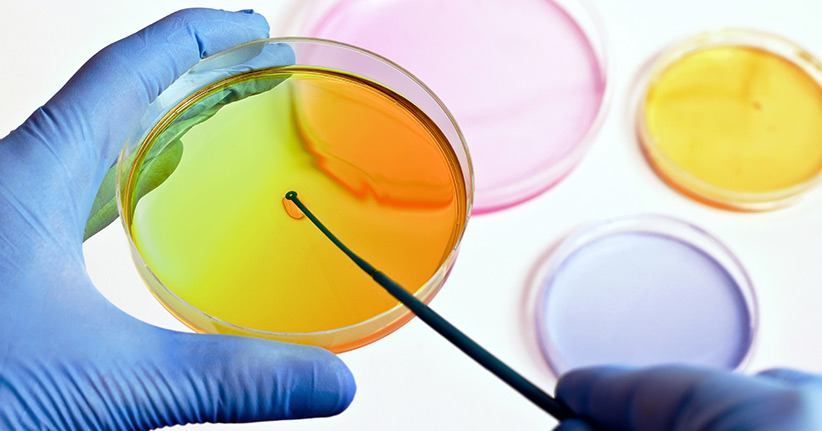
Was sind Mikroorganismen?

Die erste Hilfe bei Kopfverletzungen kann unter Umständen lebensrettend sein. Deshalb ist es ganz wichtig zu wissen, was man bei einer Kopfverletzung an Maßnahmen einleiten muss. Krankenhausaufenthalte und mehrtägige Überwachungen sind in allen Fällen sinnvoll.
Was tun gegen Kopfverletzungen
Wirkt Gewalt von außen auf den Kopf ein, sei es durch einen Sturz, einen Schlag oder einen Verkehrsunfall, so kommt es im Bereich des Kopfes zu ganz unterschiedlichen Verletzungen. Babys drehen sich manchmal gerade dann, wenn sie unbeaufsichtigt sind und fallen aus ihrem Bettchen, vom Wickeltisch oder aus dem Stühlchen. Erwachsene stoßen sich den Kopf an Hinternissen oder bei einer Prügelei schlägt einer den anderen heftig auf den Kopf. Auch wer z. B. mit dem Pkw gegen ein Hindernis fährt, kann eine Kopfverletzung davon tragen.
In der Klinik erfolgt auch eine umfangreiche bildgebende Diagnostik, um die Art der Erkrankung festzustellen und Gegenmaßnahmen ergreifen zu können. Ein Knochenbruch wird im Röntgen sichtbar, während für eine Wasseransammlung oder Blutung im Schädelinneren eine Magnetresonanztomographie oder eine Computertomographie durchgeführt werden.
Gehirnerschütterung
Häufig und vergleichsweise eine leichte Verletzung ist die Gehirnerschütterung. Der Patient ist meist sofort, aber nur ganz kurz, für ein paar Sekunden oder Minuten, ohne Bewustsein. Bei Bewusstlosigkeit ist der Patient auf die Seite zu legen, damit er nicht an Erbrochenem, Schleim oder seiner eigenen Zunge ersticken kann.
Es kann sogar vorkommen, dass diese kurze Bewusstlosigkeit vom Helfer gar nicht bemerkt wird. Für eine Gehirnerschütterung sprechen Kopfschmerzen, Schwindel und manchmal eine Erinnerungslücke (Black-out). Hinzu kommen häufig Erbrechen – zum Teil mehrfach und bis zu einer Stunde nach der Verletzung – und Übelkeit. Der Patient kann müde bzw. benommen/verlangsamt wirken.
Knochenbrüche
Einen Schädelbruch erkennt man kaum an äußeren Anzeichen. Hat man jedoch den Verdacht, dass der Sturz oder Schlag besonders heftig war, kann man zur Sicherheit eine Praxis oder Klinik aufsuchen. Die Diagnostik von feinen Haarrissen im äußeren Schädelknochen erfolgt mittels bildgebender Diagnostik, vor allem Röntgen. Schädelbrüche sind recht selten, sollten aber dennoch ausgeschlossen werden, um Spätfolgen (häufiger Kopfschmerz, Migräne usw.) zu verhindern
Einen Bruch der Schädelbasis erkennt man am austretenden Blut oder wässriger Flüssigkeit (Nervenwasser) aus Mund, Nase und/oder Ohr. Ein weiteres typisches Merkmal sind Blutergüsse, die sich an einem oder beiden Augen finden, sich meist jedoch erst eine Weile nach der Verletzung einstellen. Diese Blutergüsse werden auch wegen ihres Aussehens Brillenhämatom genannt. Der Patient ist hier meist bewusstlos, auch das Auftreten von Krämpfen ist möglich. Wurden Organge des Innenohres verletzt, so können Übelkeit, Schwindel und Erbrechen auftreten.
In beiden Fällen ist hier schnell der Arzt bzw. die Notfallambulanz der nächsten Klinik aufzusuchen. Hier erfolgen dan weitere Untersuchungen, wie Röntgen, CT oder MRT. Eine offene Wunde am Kopf wird mit Hilfe einer Binde notfallmäßig versorgt, um die Blutung zu stoppen.
Prellung oder Quetschung des Gehirns
Bei einer Prellung oder Quetschung des Gehirns können die Blutgefäße platzen, die unmittelbar unter der Schädeldecke liegen. Hier kann der Bluterguss, der sich bildet, das Gehirn unter Druck setzen. Hier tritt oft sofort oder wenig später eine Bewusstlosigkeit ein. Es kann auch zunächst sein, dass der Patient erst einmal zunehmenden Kopfschmerz beklagt. Später kommen Erbrechen, Schluckauf, Lähmungen, Übelkeit sowie psychische auffällige Veränderungen hinzu. Der Patient wird entweder unruhig, desinteressiert, verlangsamt, abwesend oder sein Erinnerungsvermögen ist gestört.
Hier muss schnell in der nächsten Klinik der Druck medikamentös genommen werden. Ohne Therapie kommt es zu Bewusstseinstrübungen und im weiteren Verlauf zum Koma. Der Patient ist in akuter Lebensgefahr und eine dringende Behandlung auf der Intensivstation muss unbedingt erfolgen!
Bild: © Depositphotos.com / photographee.eu